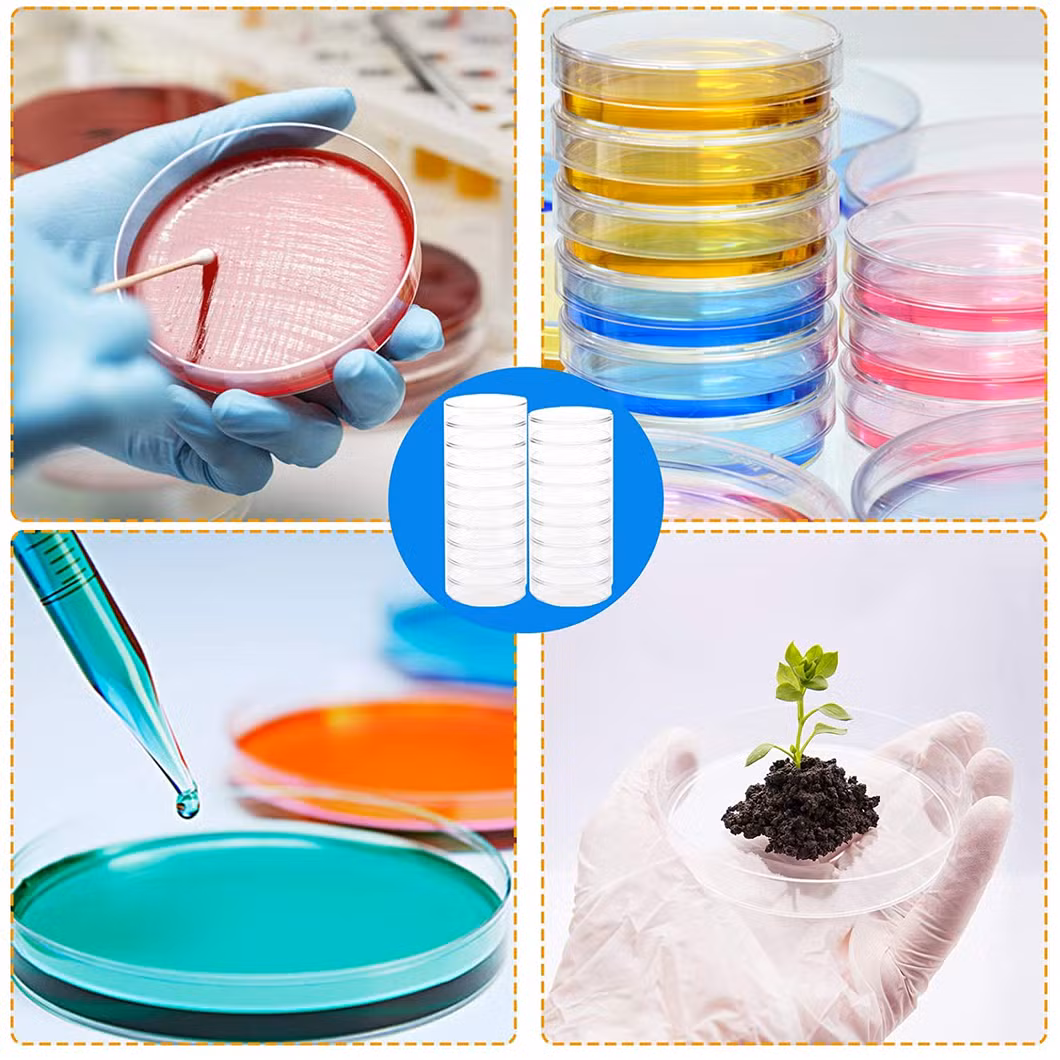

- Обзор
- описание продукта
- Подробные фотографии
- Упаковка и доставка
- Профиль компании
- Часто задаваемые вопросы
- Все продукты
- Связанные продукты
Основная Информация.
Описание Товара
Стекло CNWTC блюдо Петри | |||
Код неисправности | В нижней части dia (мм) | Высота (мм) | Крышка dia (мм) |
1177-60мм | 60 | 15 | 65 |
1177-75мм | 75 | 15 | 82 |
1177-90мм | 90 | 18 | 98 |
1177-100мм | 100 | 20 | 107 |
1177-120мм | 120 | 25 | 130 |
1177-150мм | 150 | 30 | 160 |

срок поставки и упаковка
Упаковка: мы используем коробок для защиты продуктов не ворвались.288pcs/ctn
Доставка:1.sample. Клиенты должны платить express на перевозку. Образец срок поставки составляет около 1-3 дней.
2.большой срок поставки грузов в зависимости от требований заказчика. Обычно необходимо 15-30 дней.
Чунцин новой Всемирной торговой Co., Ltd. является крупномасштабной международной торговой компании в красивом городе Чунцин. Мы
В основном специализируются на импорт и экспорт медицинское оборудование, лабораторное оборудование, химические продукты, инструментов и тяжелых металлов.
С момента создания, мы разработали стабильно и быстро. На основе устоявшихся деловых сетей и объектов, с предъявлением в качестве сотрудников
С многолетним опытом работы и а также сотрудничает со многими китайский надежных поставщиков и производителей, мы создали хороший бизнес
Сотрудничество с клиентами в более чем 50 странах и регионах, в том числе Европы, Америки, Азии и Африки, а также на Ближнем Востоке.
"Первый" всегда является целью нашей службы. "Постоянного внедрения новшеств и взгляд в будущее" - это наша цель. Мы пытаемся все возможное для
Обеспечивают лучшую продукцию и услуги для вас. С вашим любезно сотрудничества, Чунцин новой Всемирной торговой Co., Ltd. будет иметь красивый будущих
Q1: Какие выплаты вы болеете?
A:сэр,мы поддерживаем L/C,T/T,PayPle,Вестерн Юнион.
Q2: У вас есть сертификаты?
А у нас есть CE,ISO.
Q3: Можете ли вы гарантировать вашу продукцию" качества?
A:мы можем гарантировать наши продукты" качество печати хорошее.
Q4:как о?
A:образец бесплатно,он будет на arirve destinaiton в течение 3-7 дней FEDEX DHL UPS.
Небольшое количество,он прибудет на место назначения в течение 5-10 дней по воздуху.
Большое количество,он прибудет на место назначения в течение 25-35 дней на море.
Q5: Не могли бы вы дать мне самую лучшую цену?
A:конечно,мы дадим вам по наиболее выгодной цене.



Сбор крови трубы мочи емкость 10 мл Cryovial трубки